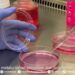
Dies Natalis Ke-63 UB Dorong Jamu Modern Berbasis Riset Terukur

Oleh : Setyo Widagdo*
Bukan Trump kalau tidak konfrontatif, menggunakan gaya komunikasi tanpa filter, blak blakan, bahkan cenderung arogan dan tidak segan merendahkan lawan politik. Sikap ini bukan sekedar perilaku pribadi, melainkan bagian dari brand kepemimpinan yang Ia bawa ke panggung dunia. Dengan demikianTrump memposisikan dirinya sebagai pemimpin yang autentik.
Memasuki awal tahun 2026, diskursus mengenai “kepongahan” dalam kebijakan luar negeri Amerika Serikat (AS) kembali memuncak. Istilah ini bukan sekadar kritik emosional, melainkan sebuah analisis terhadap pola perilaku AS yang cenderung mengabaikan konsensus internasional demi ambisi unilateral.
Arogansi AS nampak sekali pada perilaku dan kebijakan Presiden Donald Trump, terutama terhadap negara-negara yang posisi politiknya lemah. Pada periode keduanya (2025-2026), karakter ini semakin terlihat kuat melalui caranya menyusun pemerintahan. Ia cenderung mengelilingi dirinya dengan orang-orang yang sangat setia (loyalist) daripada penasihat tradisional yang berani mengkritiknya. Hal ini memperkuat kesan bahwa ia memimpin dengan otoritas mutlak.
Sejak dimulainya masa jabatan kedua Donald Trump pada tahun 2025, dunia menyaksikan kembalinya doktrin “America First” dalam bentuk yang lebih agresif. Kebijakan ini tidak lagi hanya bersifat proteksionis secara ekonomi, tetapi juga intervensionis secara militer dan politik tanpa memedulikan kedaulatan negara lain, misalnya kebijakan yang paling akhir adalah terhadap Venezuela.
Sebagaimana telah menjadi headlines berita beberapa hari ini, AS secara sepihak melakukan intervensi militer untuk menggulingkan rezim Nicolás Maduro dengan dalih mengamankan pasokan minyak dan “menegakkan demokrasi” dianggap sebagai puncak dari apa yang disebut para pengamat sebagai “politik koboi.”, sekaligus mengkormasi sikap arogansi itu.
Arogansi yang lain adalah Keputusan AS untuk kembali menarik diri dari Organisasi Kesehatan Dunia (WHO) dan Perjanjian Iklim Paris menunjukkan sikap masa bodoh terhadap krisis kolektif global. AS organisasi-organisasi internasional tersebut tidak menguntungkan secara finansial.
Demikian juga penerapan tarif bea masuk yang tinggi (25% untuk Kanada dan Meksiko) menunjukkan bahwa AS tidak lagi membedakan antara lawan geopolitik dan mitra strategis.
Kebijakan luar negeri yang dianggap pongah ini menciptakan kesenjangan antara maksud yang diklaim AS dan bagaimana dunia melihatnya. AS merasa kebijakannya paling benar, dan Trump enggan dikoreksi.
Kepongahan kebijakan luar negeri AS justru menjadi katalisator bagi runtuhnya dominasi mereka sendiri. Alih-alih menundukkan dunia, tindakan sepihak Washington mendorong negara-negara lain untuk mencari alternatif.
Lihatlah misalnya negara-negara seperti Brasil, Rusia, India, China, dan Afrika Selatan semakin solid dalam membangun sistem keuangan yang terlepas dari pengaruh Dollar AS (de-dollarization). Hal ini sekaligus merupakan penguatan bagi BRICS ++.
Negara-negara di Eropa dan Asia Tenggara (seperti Indonesia) kini lebih berhati-hati dan memilih kebijakan luar negeri yang “bebas aktif” daripada harus terseret dalam agenda unilateral AS yang tidak terprediksi. Bahkan bukan tidak mungkin telah terjadi erosi dari sekutu-sekutu AS.
Dengan mengabaikan rules-based order yang mereka ciptakan sendiri setelah Perang Dunia II, AS kehilangan otoritas moral untuk mengkritik pelanggaran hukum internasional oleh negara lain.
PENUTUP
Secara keseluruhan, “arogansi” Trump adalah alat politik yang sengaja digunakan untuk mendisrupsi tatanan lama. Ia membangun narasi bahwa dunia adalah tempat yang keras, dan Amerika membutuhkan pemimpin yang “keras” (bahkan sombong) untuk menang.
Kebijakan luar negeri yang didasarkan pada perasaan superioritas (exceptionalism) seringkali berakhir pada isolasi. Di tahun 2026 ini, AS tampak sedang berdiri di persimpangan jalan, terus memaksakan kehendaknya melalui kekuatan otot, atau mulai belajar berdialog dengan rendah hati dalam dunia yang sudah semakin plural dan multipolar. Tanpa adanya pergeseran menuju diplomasi yang empatik, kepongahan ini mungkin akan menjadi bab penutup dari era hegemoni Amerika.(*)
Penulis adalah Guru Besar Hukum Internasional dan pemerhati geopolitik Fakultas Hukum UB – [email protected]